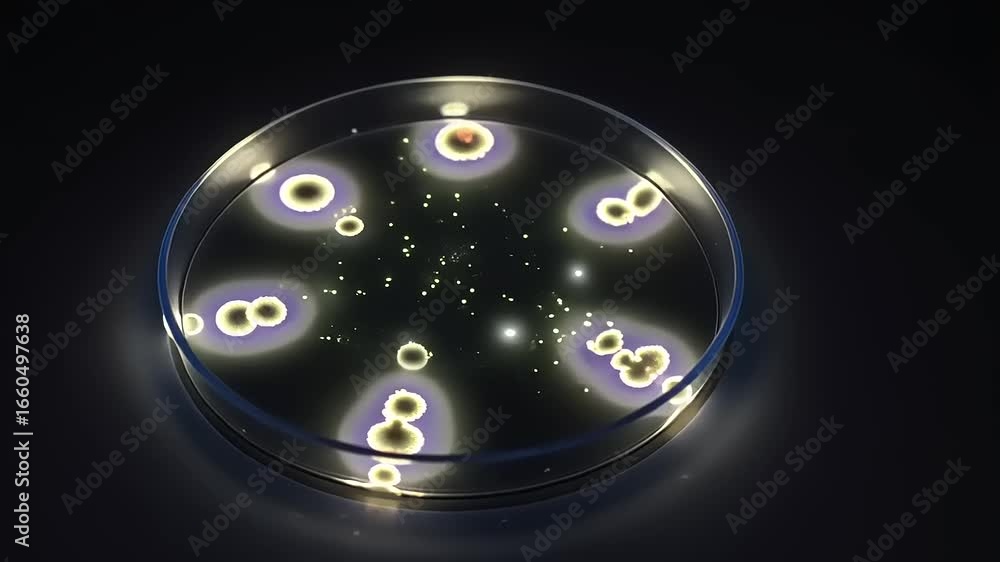

Votre panier est vide!
LIVRAISON GRATUITE PARTOUT | 30% De Réduction Sur Tout Le Site !
LIVRAISON GRATUITE |
DEVENIR DÉTAILLANT
| CALCULATEUR DE PRIX
LIVRAISON GRATUITE PARTOUT | 30% De Réduction Sur Tout Le Site !
LIVRAISON GRATUITE |
DEVENIR DÉTAILLANT
| CALCULATEUR DE PRIX
about
CALCULATEUR DE PRIX
- ×
-
Voir les catégories d'images
Il est important d'ajouter 2 pouces de matériel supplémentaire en largeur et en hauteur pour faciliter l'installation lors du recouvrement d'un mur complet. Pour une couverture partielle du mur, entrez des mesures précises.

Support
Pellicules pour vitrages
© Decomurale 2026 Tous droits réservés | Kanguru Digital Agency

Il y a 1 articles dans votre panier
Tout (Taxes incl) : $324